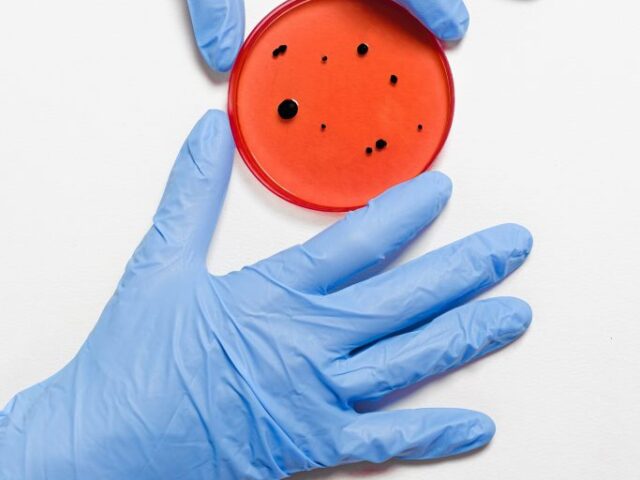
Corona Virus: A Public Service Announcement From The Office of the Hypnotist!

Blog Articles
Corona Virus: A Public Service Announcement From The Office of the Hypnotist!
The markets are down, the fear level is rising, and the truth that is spoken is slightly muffled behind the “precautionary” N95 face mask! One of the curses of modern communications is that you have so many instantaneous sources of information, not all of it is always accurate since the...
Read More
Fibromyalgia: Hypnosis Ahead of The Research – A Dallas Hypnotist Takes a Look!
Not that long ago I had the Father of a wheelchair-bound client come to my door. He rang the bell at the appointed time of my client’s Hypnosis session. I opened the door, saw that he was alone and I feared the worst. But, to my surprise, he was smiling....
Read More
Fear of Flying – How Any Fear is Not About the Thing You are Afraid Of!
Vacations, business travel, family obligations whatever it is that prompts you to board a plane these days, you’re not alone on that flight into the wild blue yonder, according to the Federal Aviation Administration, 2.5 million people travel by air every day. That works out to 43,290 average daily flights...
Read More
What Others Think of You, Why Does it Mean So Much? A Dallas Hypnotist Takes a Look!
“When you’re 20, you care what everyone thinks. When you’re 40 you stop caring what everyone thinks. When you’re 60, you realize no one was ever thinking about you in the first place,” Whether it was Winston Churchill who said those words or whether he was quoting them from someone...
Read More
A Snapshot of a Changed Life, What Yelp and Google Reviews Show – A Dallas Hypnotist Takes a Look!
I’ve said this before, but it bears repeating – “A small business like Family First Hypnosis lives and breathes through its reputation. Advertising is an expensive luxury, but one of the best ways to get the word out is by reviews on Yelp and Google”. It’s the modern-day “word of...
Read More
Panic attacks -Don’t Manage or Medicate, Fix the Root Cause! A Dallas Hypnotist Takes a Look
Are you having a Panic attack? If so, then you might want to read very closely. Panic attacks can be completely resolved. You do not have to continue to suffer with them. That’s right, Numerous people have completely overcome panic attacks for good, and very quickly. But, many medical and...
Read More
Nail-Biting, Thriller, Tragedy or Possibly a Happy Ending? A Dallas Hypnotist Takes a Look
Have you ever heard of a movie being described as “nail-biting”? It’s a description that is usually applied to thrillers, but the actual behavior of nail-biting could better be described as a tragedy to the person suffering from it. Nail-biting or to use its proper name, Onychophagia, is thought to...
Read More
Why Junior Won’t Leave, Adult Kids at Home- A Dallas Hypnotist Takes a Look!
According to a recent study by the US Census Bureau, one-third of young people aged 18 to 34 still reside with their parents. That’s about 24 million people and as shocking as that seems, the study also revealed that at least one in four (of that 24 million who live...
Read More
The Fear of Public Speaking; When to Speak Up and Fix It! – A Dallas Hypnotist Takes a Look.
According to Psycom.com, Glossophobia, or the fear of public speaking, is more common than you might think and is believed to affect up to 75% of the population. In my Hypnosis practice, I’ve seen varying degrees of this fear. Some people have no problem speaking in front of strangers, but...
Read More
Sports Performance; When “Choking” is NOT an Option – A Dallas Hypnotist Takes a Look!
The rising cost of college tuition has forced many parents and students to depend on the promise of sports-related scholarships to make ends meet. Unfortunately, the lure of taking that financial route may have some drawbacks. For example, the high expectations of pushing for “scholarship performance” can take something that...
Read More
Valentine’s Day Aftermath, You Need to Leave, But Just Can’t Go – A Dallas Hypnotist Takes a Look
Saint Valentine’s Day has come and gone and quite a few people are thinking that the whole idea of “gone” is something they should consider. So, if you are one of them and by that I mean you are faced with the painful truth of realizing that your relationship is...
Read More
Perpetual Valentine’s Day: Competitive Love! A Dallas Hypnotist Takes a Look!
What if there was a way to have that magical Saint Valentine’s Day feeling every day? Well, it’s actually possible, and in this blog, I’m going to give you one of my special secrets on just how you can create that special warmth, love and appreciation almost all the time...
Read More
Valentine’s Day as a Single, Doesn’t Mean You’re Unloved – A Dallas Hypnotist Takes A Look!
Out of all of the 365 days in a year (except this leap year of 2020, then its 366!) there is only one day across the nation and across the world that can bruise your ego and break your heart if you let it! It’s, of course, Saint Valentine’s Day,...
Read More
Valentines Day; Where Did the Love Go? How to rekindle Relationships – A Dallas Hypnotist Takes a Look
There are hearts and roses everywhere, there are commercials showing loving couples doing romantic things and there’s always the latest silly (but catchy!) love song on the radio that you just can’t seem to get out of your head. Yes, it’s almost Saint Valentine’s Day again, the second-biggest spending day...
Read More
Saint Valentine’s Day Validation; Why it’s so Important to Women – A Dallas Hypnotist Explains
It’s that time of the year again, hugs and kisses roses and chocolates, champagne and dancing the night away while staring deep into your loved one’s eyes, right? Saint Valentine’s Day is fast approaching, a day of love, a day of appreciation and for some a day of desperately needed...
Read More